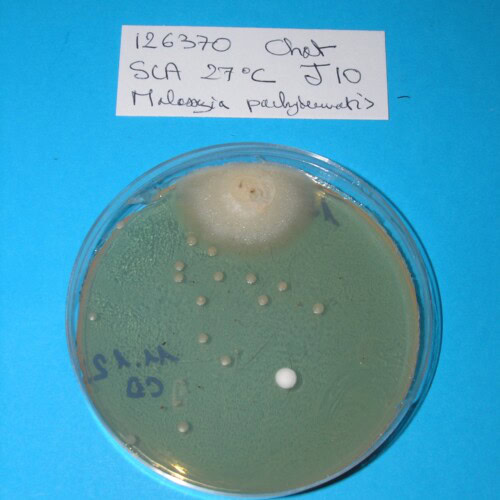

Pickle est un chat mâle castré Européen de 4 ans, tigré brun et blanc à poils mi-longs. Les propriétaires prennent rendez-vous à la clinique car ils pensent que leur chat est hyperthyroïdien et souhaitent obtenir un traitement.
Charlotte LEPOURRY
Octobre 2024
Commémoratifs
Pickle est vacciné contre le typhus, le coryza, la leucose féline et la rage. Il vit à la campagne, en maison avec un libre accès au jardin, mais sort très peu.
Il est en contact avec un autre chat.
Leurs derniers vermifuges remontent à plusieurs mois, mais ils reçoivent un traitement anti-puces régulier mensuel à l’aide de pipettes de fipronil.
Pickle refuse les croquettes, il est donc nourri avec une alimentation ménagère, qui varie selon ce que mangent les propriétaires.
Anamnèse
Les propriétaires rapportent de nombreux symptômes gênants qui affectent Pickle, présents depuis plusieurs semaines et ayant tendance à l’aggravation.
Il est agité et réclame constamment à manger et à boire, malgré cela il a perdu du poids. Il urine et défèque dans la maison tous les jours.
Les symptômes dermatologiques inquiètent peu les propriétaires, mais ils nous signalent quand même qu’il perd ses poils. Nous apprenons de plus que Pickle a depuis « toujours » des petites croûtes, sur la tête notamment, sans que cela n’ait jamais motivé de consultation. Le prurit est par ailleurs décrit comme intense et habituel ! Pickle se lèche presque en permanence. Ils ne savent pas si les lésions l’ont précédé ou non.
Ni l’autre chat ni les propriétaires ne présentent de symptômes dermatologiques.
Examen clinique
Examen clinique général
Pickle pèse 4,2kg avec un état corporel correct malgré l’amaigrissement. C’est un chat très peureux et non examinable vigile. Il est donc sédaté à l’aide de butorphanol et médétomidine.
Photo 1 : Vue d’ensemble du chat sous sédation
L’examen clinique général ne montre pas d’anomalie hormis une discrète hypertrophie des nœuds lymphatiques superficiels, notamment inguinaux.
Aucun nodule thyroïdien n’est palpable.
Examen clinique dermatologique
Examen dermatologique à distance
L’alopécie est franche et totale sur toute la zone ventrale du corps ainsi que sur la face interne des membres.

Photo 2 et 3 : Vue de la zone ventrale du corps, partie antérieure (à gauche) et partie postérieure (à droite) : notez l’hypertrophie des nœuds lymphatiques inguinaux
Elle est diffuse au niveau de la zone dorso-lombaire, du cou et de la tête. On note de l’érythème en région cervico-faciale.
Photos 4,5 et 6 : Vue de la tête, profil gauche ; vue du dessus de la région cervicale et vue de la zone dorso-lombaire
Les poils blancs restants sont jaunis par le léchage.
Examen dermatologique rapproché
Des papules sont disséminées sur toute la surface du corps. Elles sont croûteuses en zone dorsale et confluent parfois en plaques érythémateuses et surélevées en zone ventrale, où elles peuvent être surmontées de croûtes fines, adhérentes et brunâtres.
La peau du ventre est luisante et grasse par endroit.
Photos 7 et 8 : Vues rapprochées de la peau du ventre (à gauche) et sous le pavillon auriculaire gauche (à droite)
Des sécrétions cérumineuses sont présentes dans les conduits auditifs externes. Les tympans, visualisés par otoscopie directe, ne présentent pas d’anomalie. Au réveil, les réfléxes audito-podal et oto-podal sont testés, et inexistants.
Photo 9 : Vue de l’entrée du conduit auditif gauche
Figure 1 : Silhouettes lésionnelles
Bilan clinique
Dermatose chronique généralisée fortement prurigineuse caractérisée par :
En zone dorsale : une alopécie diffuse, des papules croûteuses et un érythème;
En zone ventrale : une alopécie franche avec peau luisante et séborrhéique, des papules parfois confluentes et surmontées de croûtes adhérentes brunâtres;
Des sécrétions cérumineuses.
Hypothèses diagnostiques
L’aspect d’une dermatite miliaire prurigineuse généralisée nous évoque en premier lieu une dermatite par hypersensibilité (aux puces, alimentaire ou un syndrome atopique), ainsi qu’une pyodermite superficielle et une dermatite à Malassezia. Doivent également être suspectés des ectoparasites, une dermatophytose et une démodécie.
Enfin une atteinte systémique est envisagée : infection par le virus de l’immunodéficience féline, et bien que le chat soit jeune, hyperthyroïdie compte-tenu de l’amaigrissement, de la polyphagie et de la malpropreté urinaire et fécale rappportés et une alopécie paranéoplasique étant donné l’alopécie totale et luisante de la zone ventrale.
Afin de minimiser la manipulation de Pickle et profiter de la sédation du jour de la consultation, les propriétaires acceptent l’intégralité des examens complémentaires proposés.
Examens complémentaires
Examens à interprétation immédiate
Trichoscopie (démodécie, dermatophytose) et examen à la lampe de Wood (dermatophytose à M. Canis)
L’examen à la lampe de Wood ne montre pas de poils fluorescents.
Le trichogramme montre des apex tous fracturés, à relier au léchage intense.
Il n’est pas observé de poils teigneux ni de Demodex.
Raclages cutanés (parasites profonds), peignage (parasites superficiels)
Auncun parasite n’est visualisable.
Cytologies cutanées (pyodermite superficielle, dermatite à Malassezia)
Un calque cutané est réalisé en apposant une lame dégraissée sur la peau du ventre. La lame est séchée à l’air libre puis colorée à l’aide d’un kit de coloration rapide (RAL® 555).
Nous pouvons observer de très nombreux granulocytes neutrophiles, dont la plupart sont dégénérés, de nombreux granulocytes éosinophiles ainsi que de très nombreuses coques extra et intra-cellulaires.
Photos 10 et 11 : Granulocytes neutrophiles et coques extra cellulaires (photo de gauche) et intracellulaires (photo de droite) observés en microscopie optique à l’objectif à immersion (coloration RAL®555)
Photos 12 et 13: Granulocytes éosinophiles observés parmi de nombreux granulocytes neutrophiles (photo de gauche) ainsi que de très nombreuses coques (photo de droite)
Microscopie optique, objectif à immersion (coloration RAL®555)
Des rubans adhésifs sont apposés au niveau du ventre, de la zone interscapulaire et de la zone lombaire, puis ils sont colorés par du Bleu RAL®555. De nombreuses Malasseziae sont observées au microscope optique ; elles sont particulièrement abondantes au niveau de la zone ventrale.
Photos 14 et 15 : Malasseziae observées en microscopie optique prélevées au ruban adhésif cristal sur une zone séborrhéique du ventre (objectif x 400 à gauche et x1000 à droite)
Bilan hémato-biochimique et test FeLV/FIV (maladie systémique)
Un SNAP® Combo plus FeLV/FIV se révèle négatif à la fois vis-à-vis de l’Ag du FeLV et des anticorps du FIV.
Les analyses sanguines biochimiques ne montrent pas d’augmentation des PAL, ce qui n’est pas en faveur d’une hyperthyroïdie. Par contre l’augmentation de l’urée sans augmentation de la créatininémie laisse penser que le chat est légèrement déshydraté. Des pertes hydriques cutanées importantes partiellement compensées par une polydipsie pourraient expliquer cette déshydratation.
|
Urée |
0,86 g/L (0,1-0,6) |
|
Créatininémie |
14 mg/L (5-18) |
|
Protéines totales |
65 g/L (57-94) |
|
Glycémie |
1,5 g/L (0,7-1,5) |
|
Bilirubine totale |
2,3 mg/100mL (1-3) |
|
ALAT |
24 UI (0-100) |
|
PAL |
13 UI (0-100) |
Tableau I : Résultats de la biochimie sanguine
La numération formule sanguine montre une leucocytose par neutrophilie qui est compatible avec une infection cutanée.
|
Leucocytes |
23,2.109/L (5-18) |
|
Lymphocytes |
2,69.109/L (1-6) |
|
Monocytes |
0,97.109/L (0-5) |
|
Granulocytes neutrophiles |
19,13.109/L (3-11) |
|
Granulocytes éosinophiles |
0,39.109/L (0-6) |
|
Granulocytes basophiles |
0,1 % (0-0,4) |
|
Hématies |
5,87.1012/L (5-10) |
|
Hématocrite |
27,4 % (28-45) |
|
TCMH |
15,3 pg (13-17) |
|
CCMH |
32,8 g/dL (31-35) |
|
Hémoglobine |
9 g/dL (9-15) |
|
Plaquettes |
427.109/L (150-500) |
Tableau II : Résultats de la numération formule sanguine
La concentration plasmatique de T4 totale est de 21 nmol/L, ce qui est dans les normes usuelles et écarte une hyperthyroïdie.
Examens à interprétation différée
Examen histopathologique cutané (alopécie paranéoplasique, démodécie)
Trois biopsies cutanées sont réalisées sous sédation et anesthésie locale, deux au niveau ventral et une au niveau interscapulaire, à l’aide d’un biopsy punch de 8 mm.
Par ailleurs des cytoponctions ganglionnaires sont effectuées au niveau des nœuds lymphatiques inguinaux particulièrement hypertrophiés, à l’aide d’une aiguille 23 Gauge montée sur une seringue de 5 mL. Le matériel est étalé sur des lames de microscope dégraissées qui sont séchées à l’air libre.
Les prélèvements sont traités par le laboratoire d’histopathologie cutanée d’ONIRIS.
L’examen histopathologique met en évidence une dermatite périvasculaire marquée, focalement pustuleuse. L’infiltrat dermique est riche en granulocytes neutrophiles, éosinophiles et en mastocytes.
L’aspect histologique n’est pas compatible avec une alopécie paranéoplasique.
Photo 16 : Examen histopathologique cutané (coloration HES) :
notez l’infiltration dermique par de nombreux mastocytes
Photo 17 : Examen histopathologique cutané (coloration HES) :
pustule neutrophilique intra-épidermique
L’examen des cytologies ganglionnaires ne révèle pas d’anomalie.
Culture fongique (dermatophytose, dermatite à Malassezia)
Un carré de moquette stérile est frotté sur tout le pelage du chat et envoyé au laboratoire DPM d’ONIRIS.
Aucun dermatophyte ne pousse après culture sur milieu SCA. En revanche, cet examen met en évidence de nombreuses colonies de Malassezia pachydermatis.
Photo 18 : Aspect en culture de 18 colonies de Malassezia pachydermatis (verso) ;
1 contaminant est présent en haut de la boîte de pétri – Milieu de SCA
(cliché Laboratoire DPM ONIRIS)
Photo 19 : Examen microscopique de la culture après coloration au bleu lactique (technique du drapeau de Roth)
(cliché Laboratoire DPM ONIRIS)
Diagnostic
Les examens complémentaires nous ont permis d’éliminer une atteinte systémique, des ectoparasites, une dermatophytose et une démodécie.
Le diagnostic est donc celui d’une dermatite à Malassezia et d’une pyodermite superficielle généralisées, secondaires à une dermatite par hypersensibilité dont l’origine reste à déterminer : aux puces (n’oublions pas que l’absence de puces et de déjections dans le pelage n’infirme pas l’hypothèse), alimentaire ou environnementale.
Discussion
Le syndrome cutané atopique félin (SCAF) est un diagnostic d’exclusion uniquement, et il ne peut être validé qu’après une démarche diagnostique rigoureuse écartant les autres causes de prurit et impliquant activement les propriétaires. Cette démarche prend souvent plusieurs semaines. Chez Pickle, les surinfections étaient une cause majeure de prurit. C’est la persistance du prurit après leur prise en charge thérapeutique et l’absence de résolution sous anti-parasitaire strict et régime d’éviction qui nous a permis d’aboutir au diagnostic définitif de SCAF.
La présence de granulocytes éosinophiles à la cytologie et à l’histopathologie et de mastocytes à l’histopathologie sont certes en faveur d’une hypersensibilité, mais absolument pas diagnostique d’un SCAF.
D’ailleurs l’examen histopathologique ne permet pas non plus le diagnostic d’une dermatite à Malassezia, notamment compte-tenu du processus utilisé qui fait disparaître partiellement la couche cornée et ne permet donc que rarement d’observer les levures. Pour Pickle, son intérêt a été d’écarter une alopécie paranéoplasique et une démodécie qui n’aurait pas été diagnostiquée par les raclages, souvent négatifs chez le chat.
Les dermatites à Malassezia félines, et dans une moindre mesure les pyodermites félines, sont réputées rares. Elles sont effectivement rencontrées moins fréquemment que chez le chien mais sont peut-être également sous-diagnostiquées.
Cela pourrait s’expliquer par le manque de sensibilité de certains examens complémentaires à diagnostiquer une dermatite à Malassezia, notamment les calques par apposition. Dans le cas présent, les calques réalisés lors de la première consultation n’avaient montré aucune levure. Seuls les TRAC colorés ont révélés les nombreuses Malasseziae. Il ne faut donc pas les remplacer par une apposition de lame et lorsqu’ils sont négatifs, réaliser une culture fongique pour lever le doute.
A contrario, il faudra se méfier d’un diagnostic par excès, puisque le portage de Malassezia peut être asymptomatique selon les zones corporelles prélevées et qu’aucune norme n’a été établie dans l’espèce féline pour définir un seuil de pathogénicité. Il convient donc de correctement sélectionner les individus suspects de dermatite à Malassezia, via un examen clinique de qualité, pour interpréter les examens complémentaires convenablement (c’est là tout l’art du vétérinaire !). En particulier, il semblerait que l’association alopécie / érythème / croûtes brunâtres grasses et adhérentes soit très évocatrice de dermatite à Malassezia féline, puisqu’elle est présente chez les 18 chats de l’étude d’Ordeix portant sur cette dermatose. Cette présentation clinique a d’ailleurs été observée chez Pickle.
De même, pour les pyodermites superficielles félines, les critères permettant de les diagnostiquer et orientant la conduite thérapeutique mériteraient d’être précisés. Nous nous sommes basés sur la présence de bactéries intracellulaires et de signes dermatologiques compatibles pour affirmer que Pickle souffrait de pyodermite. Selon ces critères, Yu et Vogelnest obtiennent une fréquence de 20% des cas reçus en consultation dans des structures de référé, ce qui est loin d’être négligeable.
Le traitement antimicrobien topique n’a pas été possible et nous avons donc choisi un antibiotique administrable PO. Dans l’étude de Yu et Vogelnest, un chat sur trois ne répondait pas au traitement antimicrobien mis en place initialement. La très grande majorité de ces chats étaient d’ailleurs atteints ou suspects d’être atteints de syndrome atopique.
Par ailleurs, l’association d’une pyodermite superficielle avec une dermatite à Malassezia chez les chats allergiques ne semble pas si rare, puisqu’elle est retrouvée chez un chat sur trois dans l’étude d’Ordeix.
Bibliographie
Bond R., Morris D.O., Guillot J. et al. : Biology, diagnosis and treatment of Malassezia dermatitis in dogs and cats – Clinical Consensus Guidelines of the World Association for Veterinary Dermatology. Veterinary Dermatology, 2020, 31, 27-e24
Crosaz O., Legras A., Vilaplana-Grosso F. et al. : Malassezia pachydermatis overgrowth in six cats with generalized dermatitis. Veterinary Dermatology, 23 Sup 1, 26
Favrot C., Steffan J., Seewald W. et al. : Establishment of diagnostic criteria for feline nonfleainduced hypersensitivity dermatitis. Veterinary Dermatology, 2011, 23, 45-e11
Haliwell R., Pucheu-Haston CM, Olivry T. et al. : Feline allergic diseases : introduction and proposed nomenclature. Veterinary Dermatology, 2021, 32:8
Mauldin E.A., Morris D.O., Goldschmidt M.H. : Retrospective study : the presence of Malassezia in feline skin biopsies. A clinicopathological study. Veterinary Dermatology, 2002, 13, 7-14
Oliveira A. : Malassezia dermatitis in dogs and cats. Proceedings Book of 34th European Veterinary dermatology Congress, 2023, 56
Oliveira A. : Feline Atopic Syndrome. Proceedings Book of 33rd European Veterinary dermatology Congress, 2022, 18
Ordeix L., Galeotti F., Scarampella F. et al. : Malassezia spp. overgrowth in allergic cats. Veterinary Dermatology, 2007, 18, 316-323
Santoro D., Pucheu-Haston CM, Prost C. et al. : Clinical signs and diagnosis of feline atopic syndrome : detailed guidelines for a correct diagnosis. Veterinary Dermatology, 2021, 32:26
Wildermuth B.E., Griffin C.E., Rosenkrantz W.S. : Feline pyoderma therapy. Clinical Technical Small Animal Practice, 2006, 21(3), 150-156
Yu H.W., Vogelnest L.J. : Feline superficial pyoderma : a retrospective study of 52 cases (2001-2011). Veterinary Dermatology, 2012, 23, 448-e86